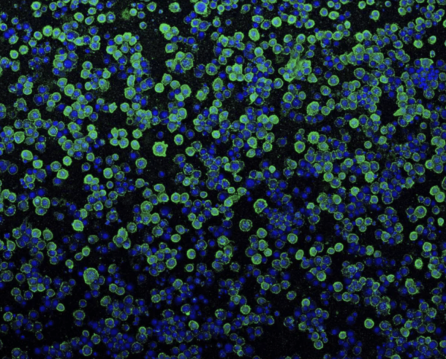

Meet the Nano-Syringe that Could Revolutionize Gene Therapy
The Context: Gene therapies hold a great deal of promise for treating a wide range of diseases. For the...The Context: Gene therapies hold a great deal of promise for treating a wide range of diseases. For the gene therapy to be effective, however, proteins produced by the therapeutic gene must reach all the cell types affected by the disease. This is currently one of the greatest challenges in the field, since many cell types are inaccessible or resistant to taking up external proteins as a protection mechanism against unwanted invaders.
The Study: Leveraging a ‘nanosyringe’ found in bacteria, scientists led by NYSCF – Robertson Stem Cell Investigator Alumnus Feng Zhang, PhD, of the Broad Institute of MIT and Harvard have developed a new technique for delivering therapeutic proteins to cells. The study appears in Nature.
The Importance: This system opens the door for more effective gene therapies, as well as targeted cancer treatments, as the nanosyringe can be programmed to hone in on tumor cells.
Did you know the bacteria that makes some caterpillars glow in the dark is also their assassin? The bacteria is called Photorhabdus asymbiotica, and along with making a caterpillar look rave-ready, this microscopic gut guest uses a miniscule syringe to inject toxins into its host’s cells and leave it for dead.
Dr. Zhang often turns to the natural world to inform his studies, as he did in his pioneering work with CRISPR gene editing, and his latest project capitalizes on Photorhabdus asymbiotica’s killer nano-syringes to address one of the greatest challenges in gene therapy: its delivery to diseased cells.
“One of the major bottlenecks for gene editing is delivery,” Dr. Zhang told Nature News. “The reason we don’t see brain or kidney diseases getting tackled [with gene therapies] is because we don’t have good delivery systems.”
So when Dr. Zhang heard about the bacteria’s special syringe, it piqued his interest.
This caterpillar case “is one of the very rare examples where a bacterial thing injects into an animal cell [as opposed to into another bacterial cell],” Dr. Zhang commented in Scientific American. “We thought if this could inject into an animal cell, maybe it could work on human cells.”
Arming Bacteria with Syringes
The team started feeding E. coli bacteria genetic instructions to make little nano-syringes of its own. The E. coli was then given insect cells to infect, and it eagerly performed its hitman duties. But when presented with human cells, it became a pacifist, refusing to carry out the job.
“So then we had to figure out: How do we engineer this thing?” remarked Dr. Zhang.
The answer lay with tail fibers, the little arms that help bacteria hold onto the cell before injecting it. The team tried dozens of ways to get the tail fibers to latch, but nothing worked. It was only upon leveraging an artificial intelligence-powered software called Alpha-Fold – which predicts how proteins will position themselves in 3D space – that they found their answer. Knowing the structure of the tail fiber proteins showed them exactly how they needed to be altered, and the scientists were back in business.
Implications for the Future
Importantly, the team demonstrated that they could inject Cas9 – the protein involved in gene editing – into cells, indicating potential use in future gene therapies where a defective gene needs to be corrected. Each needle can also carry multiple copies of a protein, allowing for higher dosages.
The system was also effective in mice – by injecting it into mouse brains, the syringes successfully inserted proteins that made the neurons glow.
The syringes also have potential applications in cancer therapeutics, as they could be engineered to hone in on certain receptors present only on cancer cells.
“It doesn’t seem to kill cells that don’t contain the receptor that you’re targeting,” first author Joseph Kreitz told Genetic Engineering and Biotechnology News. “So, you could imagine an application where you’re giving patients a PVC [the entity carrying the syringe] that targets a cancer epitope and then having the system go and deactivate cells that express that cancer epitope.”
The scientists will continue testing their new system and working toward its applications in humans, including potentially building on the successful impact of mRNA technology seen in the vaccine world.
“Delivery of therapeutic molecules is a major bottleneck for medicine, and we will need a deep bench of options to get these powerful new therapies into the right cells in the body,” Dr. Zhang told . “By learning from how nature transports proteins, we were able to develop a new platform that can help address this gap.”
Journal Article:
Programmable protein delivery with a bacterial contractile injection system
Joseph Kreitz, Mirco J. Friedrich, Akash Guru, Blake Lash, Makoto Saito, Rhiannon K. Macrae & Feng Zhang. Nature. DOI: https://doi.org/10.1038/s41586-023-05870-7
Read more from:
Genetic Engineering and Biotechnology News
Top image: The bacterium Photorhabdus asymbiotica uses molecular spikes to pierce a hole in the membranes of host cells. Credit: F. Zhang et al./Nature